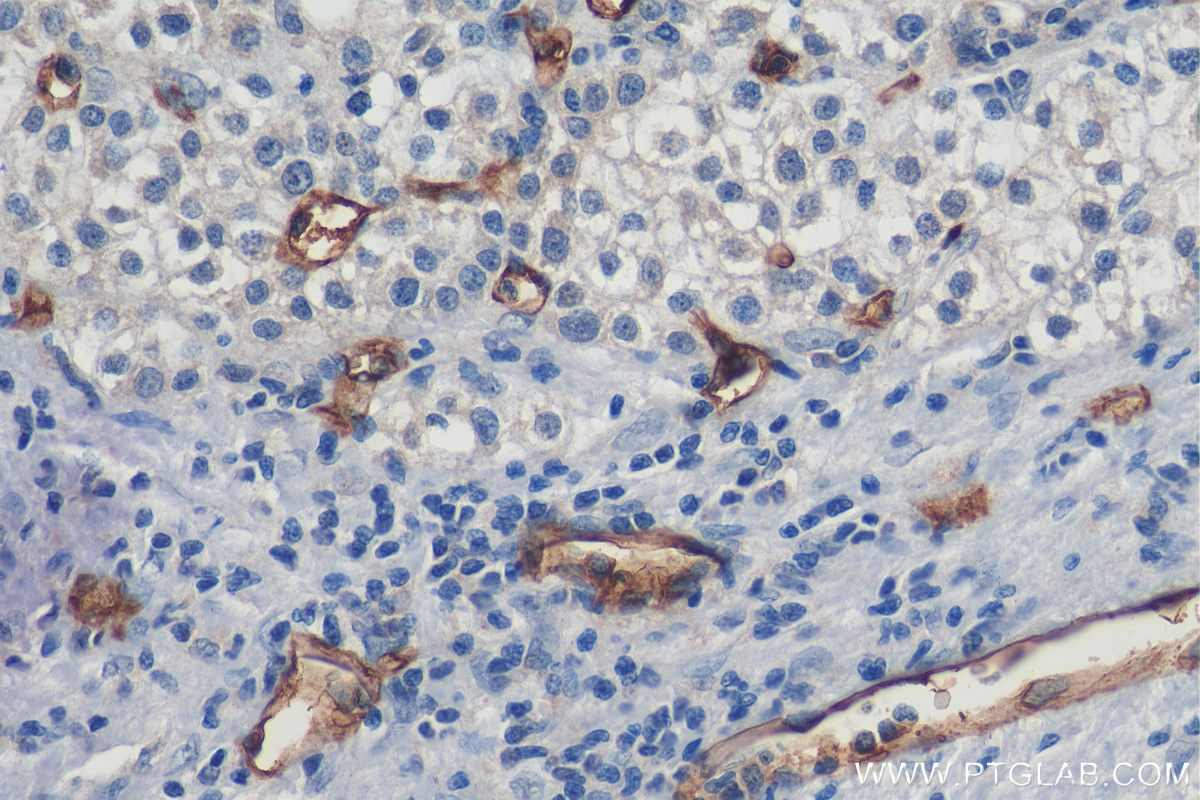

验证数据展示
经过测试的应用
| Positive WB detected in | human placenta tissue, human uterus tissue, human testis tissue |
| Positive IHC detected in | human liver cancer tissue, human placenta tissue, human tonsillitis tissue Note: suggested antigen retrieval with TE buffer pH 9.0; (*) Alternatively, antigen retrieval may be performed with citrate buffer pH 6.0 |
| Positive IF-P detected in | human placenta tissue, human tonsillitis tissue, human liver cancer tissue, human liver tissue |
推荐稀释比
| 应用 | 推荐稀释比 |
|---|---|
| Western Blot (WB) | WB : 1:1000-1:4000 |
| Immunohistochemistry (IHC) | IHC : 1:2500-1:10000 |
| Immunofluorescence (IF)-P | IF-P : 1:200-1:800 |
| It is recommended that this reagent should be titrated in each testing system to obtain optimal results. | |
| Sample-dependent, Check data in validation data gallery. | |
发表文章中的应用
| IHC | See 13 publications below |
| IF | See 8 publications below |
产品信息
60180-1-Ig targets CD34 in WB, IHC, IF-P, ELISA applications and shows reactivity with human samples.
| 经测试应用 | WB, IHC, IF-P, ELISA Application Description |
| 文献引用应用 | IHC, IF |
| 经测试反应性 | human |
| 文献引用反应性 | human |
| 免疫原 |
CatNo: Ag5996 Product name: Recombinant human CD34 protein Source: e coli.-derived, PET28a Tag: 6*His Domain: 34-287 aa of BC039146 Sequence: DNNGTATPELPTQGTFSNVSTNVSYQETTTPSTLGSTSLHPVSQHGNEATTNITETTVKFTSTSVITSVYGNTNSSVQSQTSVISTVFTTPANVSTPETTLKPSLSPGNVSDLSTTSTSLATSPTKPYTSSSPILSDIKAEIKCSGIREVKLTQGICLEQNKTSSCAEFKKDRGEGLARVLCGEEQADADAGAQVCSLLLAQSEVRPQCLLLVLANRTEISSKLQLMKKHQSDLKKLGILDFTEQDVASHQSYS 种属同源性预测 |
| 宿主/亚型 | Mouse / IgG2b |
| 抗体类别 | Monoclonal |
| 产品类型 | Antibody |
| 全称 | CD34 molecule |
| 别名 | 3C8G12, CD34 molecule |
| 计算分子量 | 41 kDa |
| 观测分子量 | 105 kDa |
| GenBank蛋白编号 | BC039146 |
| 基因名称 | CD34 |
| Gene ID (NCBI) | 947 |
| RRID | AB_10733337 |
| 偶联类型 | Unconjugated |
| 形式 | Liquid |
| 纯化方式 | Protein A purification |
| UNIPROT ID | P28906 |
| 储存缓冲液 | PBS with 0.02% sodium azide and 50% glycerol, pH 7.3. |
| 储存条件 | Store at -20°C. Stable for one year after shipment. Aliquoting is unnecessary for -20oC storage. |
背景介绍
CD34 is a 105- to 120-kDa glycophosphoprotein expressed on the majority of hematopoietic stem/progenitor cells, bone marrow stromal cells, capillary endothelial cells, embryonic fibroblasts, and some nerve tissue. CD34 is a commonly used marker for identifying human hematopoietic stem/progenitor cells and mediates cell adhesion and lymphocyte homing by binding L-selectin and E-selectin ligands. CD34 is also one of the best negative selection markers for characterizing and/or isolating human MSCs from bone marrow and other sources. Along with other positive selection markers (such as CD29, CD44, CD90, CD105 and CD166), negative selection markers (such as CD34 and CD45) are used for MSC identification. The calculated molecular mass of human CD34 is 41 kDa, various forms with different molecular weights may be produced due to different glycosylation patterns and alternative splicing (PMID: 24375067; 15750786).
实验方案
| Product Specific Protocols | |
|---|---|
| IF protocol for CD34 antibody 60180-1-Ig | Download protocol |
| IHC protocol for CD34 antibody 60180-1-Ig | Download protocol |
| WB protocol for CD34 antibody 60180-1-Ig | Download protocol |
| Standard Protocols | |
|---|---|
| Click here to view our Standard Protocols |
发表文章
| Species | Application | Title |
|---|---|---|
Gastroenterology Proteomic characterization identifies clinically relevant subgroups of gastrointestinal stromal tumors | ||
Front Immunol Thrombotic microangiopathy mediates poor prognosis among lupus nephritis via complement lectin and alternative pathway activation | ||
Front Bioeng Biotechnol Primary Repair for Treating Acute Proximal Anterior Cruciate Ligament Tears: A Histological Analysis and Prospective Clinical Trial. | ||
Exp Cell Res Nrf2 activation is involved in osteogenic differentiation of periodontal ligament stem cells under cyclic mechanical stretch. | ||
Biomed Mater The additive effects of photobiomodulation and bioactive glasses on enhancing early angiogenesis. | ||